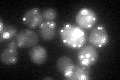
YOL126C
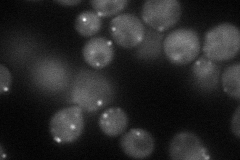
YOL126C
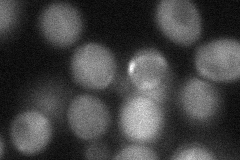
YOL126C

View description
Cytoplasmic malate dehydrogenase, one of three isozymes that catalyze interconversion of malate and oxaloacetate; involved in the glyoxylate cycle and gluconeogenesis during growth on two-carbon compounds; interacts with Pck1p and Fbp1
Localization:
Intensity:
Fold change:
Significance:
-
C’ GFP library in SD
punctate47.7 -
N' NOP1pr-GFP in SD
punctate55.7749 -
N' TEF2pr-mCherry in SD

punctate60.4364 -
N' NATIVEpr-GFP in SD

punctate102.165 -
N' TEF2pr-VC and Cyto-VN in SD
cytosol43.7412 -
C’ GFP library in SD+DTT

punctate48.91.02No -
C’ GFP library in SD+H2O2

punctate67.961.42Yes -
C’ GFP library in Starvation Media

punctate30.990.64No -
C’ GFP library on the background of Pup2-DaMP

punctate -
C’ GFP library on the background of CCT mutant

punctate44.06540.923605No
